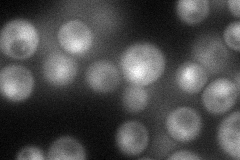
YPL007C
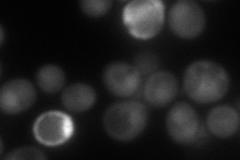
YPL007C
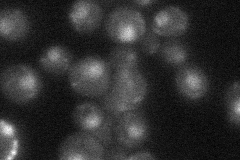
YPL007C
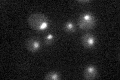
YPL007C

View description
One of six subunits of RNA polymerase III transcription initiation factor complex (TFIIIC); part of TFIIIC TauB domain that binds BoxB promoter sites of tRNA and other genes; linker between TauB and TauA domains; human homolog is TFIIIC-90
Localization:
Intensity:
Fold change:
Significance:
-
C’ GFP library in SD

nucleus23.08 -
N' NOP1pr-GFP in SD
cytosol,nucleus66.8886 -
N' TEF2pr-mCherry in SD
nucleus88.2148 -
N' NATIVEpr-GFP in SD
nucleus24.3543 -
N' TEF2pr-VC and Cyto-VN in SD

#N/A0 -
C’ GFP library in SD+DTT

nucleus251.08No -
C’ GFP library in SD+H2O2

nucleus25.231.09No -
C’ GFP library in Starvation Media
nucleus22.370.96No -
C’ GFP library on the background of Pup2-DaMP

nucleus -
C’ GFP library on the background of CCT mutant

nucleus22.11360.957761No
